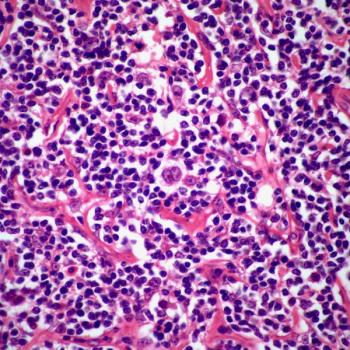
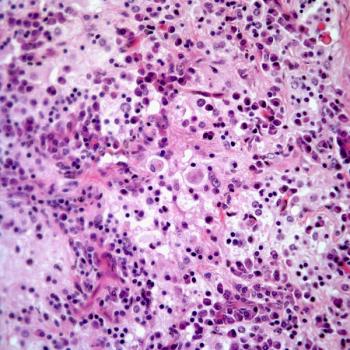
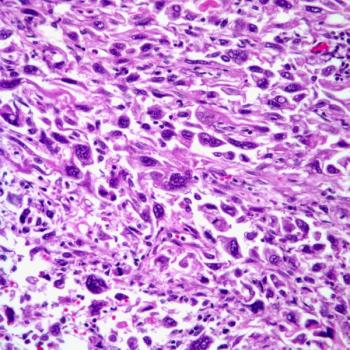
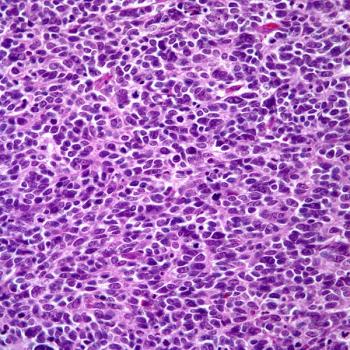

A 67-year-old man presents with a cough and history of weight loss of several weeks' duration. Chest imaging reveals the presence of a pulmonary mass. What is your diagnosis?

Your AI-Trained Oncology Knowledge Connection!


A 67-year-old man presents with a cough and history of weight loss of several weeks' duration. Chest imaging reveals the presence of a pulmonary mass. What is your diagnosis?

A 22-year-old man presents with a firm, painless nodule on his arm that is approximately 1 cm in size. No discoloration of the skin is identified. What is your diagnosis?

A 52-year-old man presents with headaches and general malaise. Diagnostic imaging shows the presence of an intracranial mass. What is your diagnosis?

A 58-year-old man presents with symptoms of chest pain and dyspnea of several weeks duration. Chest imaging shows the presence of an intrapulmonary mass. What is your diagnosis?

A 46-year-old man presents with symptoms of chest pain, cough, and hemoptysis. Chest imaging reveals the presence of a bronchial tumor. What is your diagnosis?

A 14-year-old girl presents with symptoms of dyspnea, cough, and hemoptysis. Chest imaging reveals the presence of a bronchial tumor. What is your diagnosis?

A 49-year-old woman presents with headaches. Diagnostic imaging reveals the presence of an intracranial mass. What is your diagnosis?
A 20-year-old man presents with general malaise. At physical examination a large axillary lymph node is found. Surgical resection of the lymph node is performed. What is your diagnosis?

A 53-year-old woman presents with symptoms of dyspnea, chest pain, and cough. Chest imaging reveals the presence of a bronchial tumor. What is your diagnosis?

A 72-year-old man presents with a history of cough, chest pain, and shortness of breath of several weeks duration. Chest imaging reveals the presence of an intrapulmonary mass. What is your diagnosis?

A 52-year-old woman presents with a cough and chest pain. Chest imaging reveals the presence of a coin lesion in the right upper lobe. What is your diagnosis?
A 48-year-old woman presents with a soft-tissue nodular lesion in the right forearm. Surgical resection of the lesion is performed. What is your diagnosis?

A 52-year-old man presents with inguinal lymphadenopathy. Surgical resection of the lymph node is performed. What is your diagnosis?

A 47-year-old woman presented with a cough, chest pain, and weight loss. Chest imaging reveals the presence of an intrapulmonary mass. What is your diagnosis?

A 2-year-old child develops an indurated lesion of the right buttock. What is your diagnosis?

A 42-year-old man presents with a history of coughing, dyspnea, and fatigue. Chest imaging reveals the presence of a bronchial mass. What is your diagnosis?


This kidney cancer slide show features images of chromophobe, papillary, and clear-cell renal cell carcinomas; as well as sarcomatoid, transitional cell, and small-cell carcinomas of the kidney.

A 37-year-old man presents with a skin lesion on the right side of his back. What is your diagnosis?

A 43-year-old woman presents with a mass in the left breast. What is your diagnosis?

A 37-year-old woman presents with abdominal pain. A pancreatic mass is discovered. What is your diagnosis?

A 52-year-old woman presents with neck pain. A thyroid mass is identified. What is your diagnosis?



A 62-year-old woman presents with abdominal pain. A lesion in the right adrenal gland is identified. What is your diagnosis?

A 62-year-old man presents with numerous skin lesions of the arms and abdomen. What is your diagnosis?

A 25-year-old woman presents with pain in the subungual region. What is your diagnosis?

A 23-year-old man presents with numerous enlarged neck lymph nodes. What is your diagnosis?
